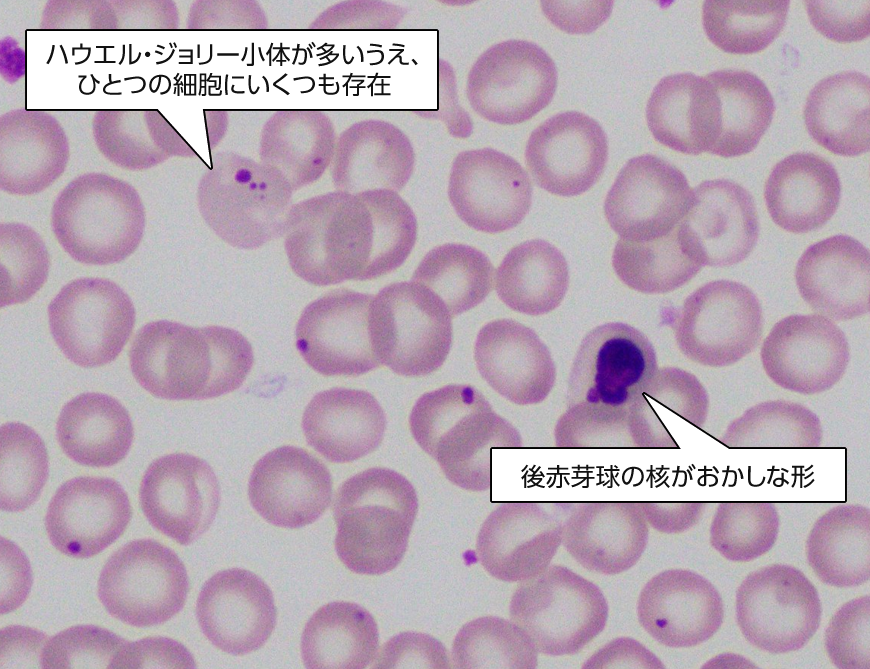
ハウエル・ジョリー小体が多いうえ、ひとつの細胞にいくつも存在／後赤芽球の核がおかしな形
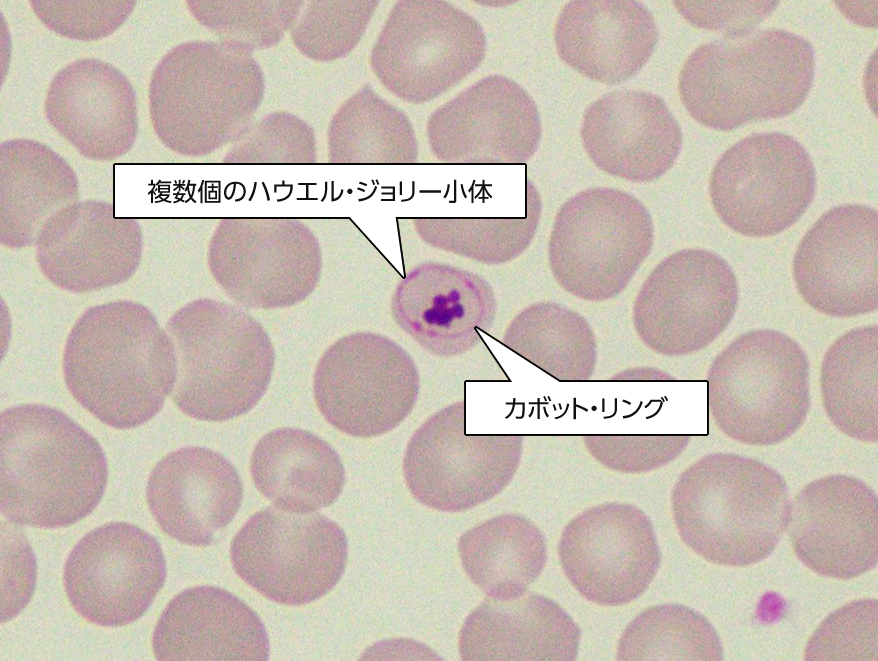
複数個のハウエル・ジョリー小体／カボット・リング

このコンテンツは獣医療従事者向けの内容です。
皆さまこんにちは。突然ですがこちらの検査データ、どう思われますか?犬、トイプードル、2歳、避妊済雌です。
| CBC | RI | |
|---|---|---|
| WBC (/μl) | 9000 | 6000-17000 |
| Neut | 4930 | 3000-11500 |
| Lym | 3420 | 1000-4800 |
| Mono | 380 | 150-1350 |
| Eos | 190 | 100-1250 |
| Baso | 30 | Rare |
| HCT (%) | 47.5 | 37-55 |
| RBC (104/μl) | 424 ↓ | 550-850 |
| HGB (g/dl) | 16.0 | 12-18 |
| MCV (fL) | 112.1 ↑ | 60-77 |
| MCHC (g/dl) | 33.7 | 32-36 |
| PLT (104/μl) | 30.2 | 20-50 |
| Retic count (/μL) | 41100 | >80000で再生 |
| Chemistry | RI | |
|---|---|---|
| TP (g/dl) | 5.6 | 5.0-7.2 |
| ALB (g/dl) | 3.5 | 2.6-4.0 |
| GLB (g/dl) | 2.1 | |
| ALT (IU/l) | 40 | 17-78 |
| AST (IU/l) | 28 | 17-44 |
| ALP (IU/l) | 41 | 0-89 |
| TCHO (mg/dl) | 183 | 115-337 |
| TBIL (mg/dl) | 0.1 | 0-0.5 |
| BUN (mg/dl) | 21.3 | 9.2-29.2 |
| Cre (mg/dl) | 1.06 | 0.4-1.4 |
| Glu (mg/dl) | 94 | 75-128 |
| Ca (mg/dl) | 10.0 | 9.3-12.1 |
| IP (mg/dl) | 2.8 | 1.9-5.0 |
| Na (mmol/l) | 149 | 141-152 |
| K (mmol/l) | 4.4 | 3.9-5.5 |
| Cl (mmol/l) | 114 | 102-117 |
| Lipase (IU/l) | 38 | 0-160 |
| CRP (mg/dl) | 0.8 | 0-0.7 |
健康状態に問題のない、若い子で、健康診断のための血液検査でみつかった異常です。ケミストリーの範囲ではとくに目立った異常がないようですが、CBCにて赤血球系の数値に異常がみられます。
⾚⾎球数が低いため「あれ、貧⾎?」と思うかもしれませんが、低いのは赤血球数のみで、ヘマトクリットやヘモグロビンの異常がなくこれらデータは乖離しています。そして特に目を引くのがMCVの高さです(犬ですと普通は60-70flくらいですが、なんと100flを超えています)。これはどういうことでしょうか。
MCVというのは、赤血球の大きさの平均値をあらわす数字で、MCV高値はすなわち赤血球が大きいということです。機械で測定するヘマトクリットは、MCVに赤血球数を掛け算して算出されます。冒頭のデータでヘマトクリットと赤血球数が乖離しているのは、MCVが高すぎる(赤血球が大きすぎる)ことが原因です。もうひとつMCVと一緒に語られることが多いのがMCHCで、こちらは赤血球の色素量をあらわす数字です。
まず、MCVやMCHCの上昇・低下原因を整理してみましょう。まずは下記の鑑別疾患リストをご覧ください。
| MCVとMCHCの変化 | 考えられうる疾患もしくは検査エラー |
|---|---|
|
正球性正色素性 |
|
|
大球性低色素性 |
|
|
大球性正色素性 |
|
|
小球性低色素性 |
|
|
小球性正色素性 |
|
|
正球性低色素性 |
|
|
高色素性 |
|
こんなふうに、MCV、MCHCがどう動くかの組み合わせで鑑別がたくさんあります。
だいぶ覚えるのが大変ですので、代表的なものをまとめた簡易版が以下です。

貧血を分類するときに使われるものです。学生時代には再生性貧血は大球性低色素性になるんだ、と習った先生がいるのではないでしょうか? これはじつは正確ではなく、いまでは再生性貧血の多くは大球性低色素性にはならないことがわかっています。これで貧血分類が完璧にできるわけではなく、所見のひとつとしてとらえておくのがいいでしょう。なお上記の表は弊社の動物医療ライブラリにある私の動画、「CBC・血液塗抹の読み方Part3」の一部です。もっと詳しく知りたいかたは是非こちらをご覧ください。
さて、冒頭のデータではMCV高値・MCHC正常です。大球性正色素性のところをみてみると、再生性貧血、猫のFeLV感染、赤血球自己凝集、プードル巨大赤血球症が鑑別として挙げられています。犬ですのでFeLVはありませんし、Reticは高くないため再生性貧血ではなさそうです。
冒頭に示した症例の答えはプードル巨大赤血球症です。名称がいくつかあり、家族性巨大赤血球症、家族性プードルマクロサイトーシス、プードル骨髄障害なども同じ意味です。英名もfamilial poodle macrocytosisなどいくつかあります。
本疾患は先天的異常の一種で、生まれつき赤血球が大きく、MCVが非常に高くなります。我が国ではトイプードルでみつかることが圧倒的に多いですが、プードル系の他犬種やプードル系交雑種(たとえばラブラドゥードルなど)でも経験することがあります。
今回のケースのように、MCV100前後、無症状でヘマトクリット減少がない・そしてプードル、という条件がそろっていれば、だいたいはこの病気であることが多いです。今回はMCV112flですが、私の経験則としては100±10くらいが一番多いです。網状赤血球は普通増えないのですが、網状赤血球も一緒に増えてしまう特殊なサブタイプもあります。ただしデータだけで決めつけず、血液塗抹像の確認、他疾患の除外を行うのが良いでしょう。
血液塗抹ではハウエル・ジョリー小体の増加や形の異常、後赤芽球の増加・形の異常、核のブリッジング、好中球の過分葉などが出ます。変な形の細胞が出るので、この病気のことを何も知らずに見たら何やら重大な病気のように思ってしまうかもしれません。ですが健康に異常をきたすわけではなく、キャバリアで有名な先天性巨大血小板血症のようにある種の個性のようなものと思ってよいと思います。
ハウエル・ジョリー小体(Howell-Jolly body)や後赤芽球(metarubricyte)の異常
複数のハウエル・ジョリー小体とカボット・リング(Cabot ring)
私は研修でお世話になった米国の臨床病理の先生たちとオンラインでお話をすることがあるのですが、プードルの巨大赤血球症、米国ではあまり見かけないとみなさんおっしゃいます。私の場合、だいたい年間1000件ほどの血液学の解釈をしておりますが、月に1回くらい(多いときには一日2件みることすら)ありまして、その話をすると結構びっくりされます。日本においてトイプードル飼育数がものすごく多いというのも当然関係しているでしょうし、それ以外になにか別の要因(特定の遺伝的素因のプードルがブリーディングされているなど)があるのかもしれません。
プードル系の子が健康診断にきたら、この疾患を少し気にしてみてみるといいかもしれません。
- Stockham, S. L., & Scott, M. A. (Eds.). (2024). Fundamentals of veterinary clinical pathology. John Wiley & Sons.
- Brooks, M. B., Harr, K. E., Seelig, D. M., Wardrop, K. J., & Weiss, D. J. (Eds.). (2022). Schalm's veterinary hematology.
- Boyd, S. P., & Best, M. P. (2018). Persistent reticulocytosis in a case of poodle macrocytosis. Veterinary Clinical Pathology, 47(3), 400-406.
【執筆:富士フイルムVETシステムズ 診断医(臨床病理) 島田優一】



